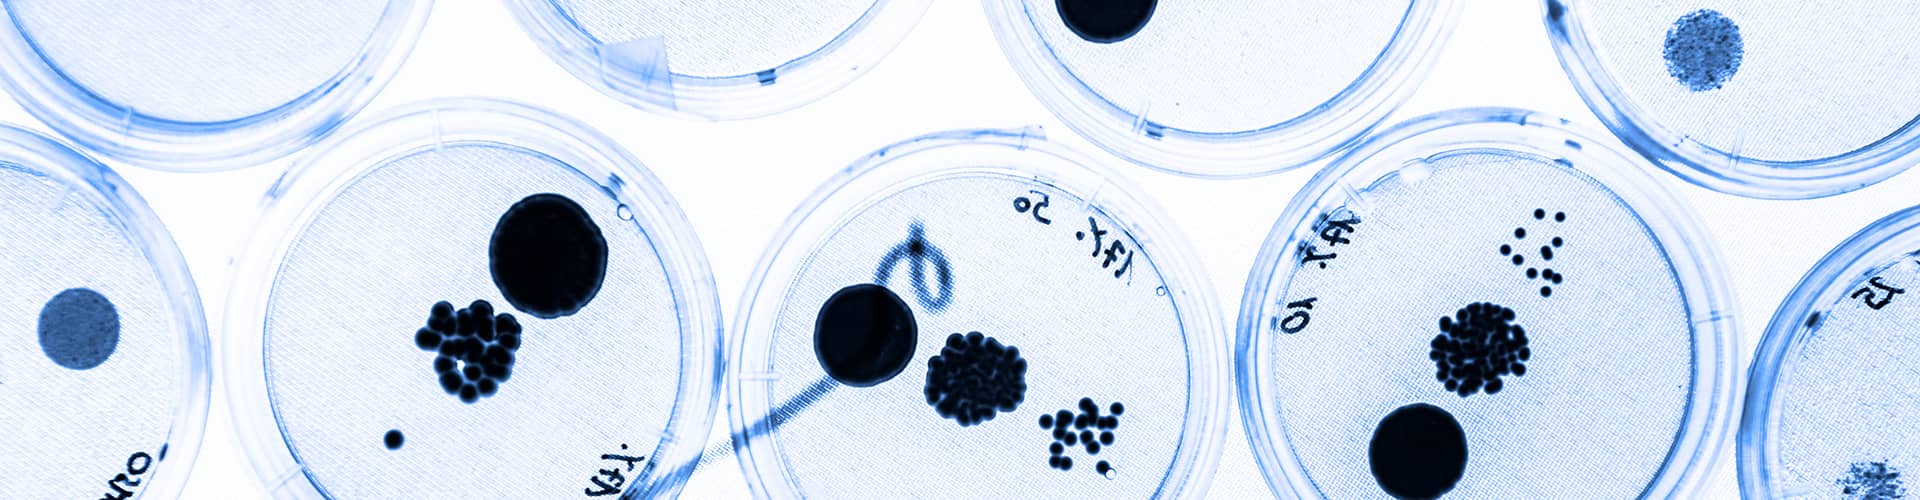

RMIT Experts available for comment on topics relating to the pandemic
Experts from RMIT University are available to talk to media about sleep habits during a time of disruption, a newly awakened corporate responsibility, and the link between access to public spaces and health.
Sleep during a time of disruption
Russell Conduit (0438 255 520 or russell.conduit@rmit.edu.au)
Topics: Sleep health, sleep habits and solutions
“The stress, and for many, lack of a normal work routine, is leading to a sharp increase in sleep problems and insomnia.
“Regularly getting a good night’s sleep is one of the most important factors for maintaining your immune system, mood and mental health.
“Sleep deprivation significantly depletes the immune system, makes people irritable and moody, and exacerbates existing mental health issues such as depression and anxiety.
“This is a recipe for disaster when isolated at home with family or roommates.
“If you find yourself up late at night, sleeping irregular hours, sleeping in the middle of the day, or sleeping very little at all, you should do something about it.
“Three simple tips to improve your sleep are maintaining a regular daily schedule; getting enough sunlight and exercise; and giving yourself ‘down time’ before bed.
”If you are really struggling to sleep, seek medical advice. Your doctor can refer you to a sleep specialist if needed.”
Dr Russell Conduit is a Senior Lecturer and Director of the School of Health and Biomedical Sciences Sleep Laboratory, RMIT University. He has worked in sleep research for the past 20 years. His research interests are in paediatric sleep health and the development of novel treatments for sleep disorders.
Corporate responsibility towards the environment and society
Dr Leanne Morrison (0429 125 362, or leanne.morrison@rmit.edu.au)
Topics: Environment, corporate environmental impact, corporate contributions to climate change, responsible business practices
“The race to profit has guided business since the industrial revolution, but if climate change has warned us that we are fast approaching the limits of that race, then COVID-19 is sounding the alarm.
“Climate Change and Coronavirus are warning signs that our way of doing business is no longer sustainable; either socially or environmentally.
“The pandemic has had profound impacts on companies across the world, with the ASX200 dropping 4.5%, the US economy contracting for the first time in six years and some controversial corporate decisions such as Virgin Australia in voluntary administration and Qantas standing down 20,000 employees.
“We need to make radical changes to the way we do business; changes which put the wellbeing of nature and people ahead of profit.
“Our response to the coronavirus demonstrates our capacity for rapid and profound transformation such as radically reducing carbon emissions, reducing our fossil fuel intensive travel habits and caring for the most vulnerable in our society.”
“Coronavirus has highlighted what is important to many of us such as good health care, a generous welfare system, and an economic framework that supports the most vulnerable in our society.
“The pandemic has opened our eyes to our own vulnerability when natural systems lose their balance.”
Dr Leanne Morrison is a researcher in the School of Accounting, Information Systems and Supply Chain at RMIT University. Her research focuses on corporate environmental impact. She is an expert in business communication about nature and corporate environmental ethics.
Access to public space promotes healthy lives
Dr Melanie Davern (0405 562 735 or melanie.davern@rmit.edu.au)
Topics: Health and urban planning, healthy cities
“As we spend a lot more time at home and in our local neighbourhoods, we are all finding out about the strengths and weaknesses in the liveability of our neighbourhoods.
“Anybody who has left their home in the past few weeks will have noticed more people are using local streets and public open spaces.
“Accessible public space is a key ingredient of healthy and liveable places and important for mental and physical health, urban cooling, biodiversity, air pollution and stormwater runoff.
“Yet, not all neighbourhoods have access to public open space within 400 metres. We see this in many neighbourhoods across cities in Australia.
“Having services and facilities close by has been shown to support walking for transport to shops and services, promote health and reduce non-communicable diseases such as heart attacks and strokes.
“However, our new lives during this pandemic also highlight inequities in local access to health, public transport, cycling and walking, community and social services are poorer in the low-density outer suburbs that are common across Australian cities. This is very evident in the liveability maps of the Australian Urban Observatory.
“This experience can teach us some lessons about how to live and plan our communities to promote good health, liveability and social cohesion, both now and after this pandemic passes.”
Dr Melanie Davern is Director of the Australian Urban Observatory in the Centre for Urban Research at RMIT.
***
For media enquiries, please contact RMIT Communications: 0439 704 077 or news@rmit.edu.au
- Urban Design
- Environment
- Society


Acknowledgement of Country
RMIT University acknowledges the people of the Woi wurrung and Boon wurrung language groups of the eastern Kulin Nation on whose unceded lands we conduct the business of the University. RMIT University respectfully acknowledges their Ancestors and Elders, past and present. RMIT also acknowledges the Traditional Custodians and their Ancestors of the lands and waters across Australia where we conduct our business - Artwork 'Sentient' by Hollie Johnson, Gunaikurnai and Monero Ngarigo.
More information